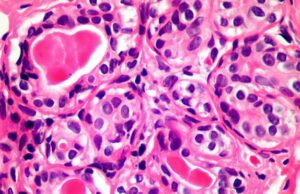
Βρετανοί φαίνεται πως ανακάλυψαν ανοσοποιητικό κυττάρο που «σκοτώνει» τον καρκίνο

admin-b
Βρετανοί φαίνεται πως ανακάλυψαν ανοσοποιητικό κυττάρο που «σκοτώνει» τον καρκίνο
Ένα νέο είδος ανοσοποιητικού κυττάρου που εξοντώνει σχεδόν όλα τα καρκινικά κύτταρα, ανακαλύφθηκε τυχαία από Βρετανούς επιστήμονες, του Πανεπιστημίου του Κάρντιφ, οι οποίοι αισιοδοξούν ότι ίσως στο μέλλον η ανακάλυψη τους αποδειχθεί ιστορική...
Πηγή μόλυνσης του περιβάλλοντος και του νερού τα ανενεργά ορυχεία
Ανενεργά ορυχεία, τα οποία κάποτε αποτελούσαν κινητήριο δύναμη της ανάπτυξης της τοπικής οικονομίας, πλέον, εκτιμάται - σύμφωνα με όσα προκύπτουν από μελέτη εμπειρογνωμόνων από εννέα...
ΠΟΥ: Έκτακτη σύγκληση του Παγκόσμιου Οργανισμού Υγείας για τον νέο κοροναϊό
Ο Παγκόσμιος Οργανισμός Υγείας ανακοίνωσε ότι συγκαλεί έκτακτη συνεδρίαση την Τετάρτη για τον νέο κοροναϊό, που εξαπλώνεται στην Κίνα και έχει πλήξει άλλες τρεις...
Το Τρόοδος το καλοκαίρι μπορεί να σας αδυνατίσει!
Νέα μελέτη του Τεχνολογικού Πανεπιστημίου Κύπρου για την ανάδειξη των δυνητικά ευεργετικών επιδράσεων του περιβάλλοντος της ευρύτερης περιοχής Τροόδους στην ανθρώπινη υγεία κατά την...
1ος Μαραθώνιος Κυβερνοασφάλειας & Κυβερνοάμυνας
O 1ος Μαραθώνιος Ανάπτυξης Λύσεων Κυβερνοασφάλειας και Εφαρμογών Ασφαλείας είναι γεγονός!
Το Κέντρο Καινοτομίας IDEA, το Υπουργείο Άμυνας, το Υπουργείο Παιδείας, η Πρεσβεία των ΗΠΑ...
ΟΗΕ: Έρχονται ακραία μετεωρολογικά φαινόμενα το 2020
H δεκαετία που πέρασε (2010-2019) ήταν η θερμότερη που έχει ποτέ καταγραφεί, ανακοίνωσε ο ΟΗΕ, επιβεβαιώνοντας το ανυποχώρητο φαινόμενο της υπερθέρμανσης του πλανήτη, που...
Ντιέγκο: Η χελώνα με τις υψηλές αποδόσεις στο σεξ που έσωσε...
Έχει κλείσει 100 χρόνια ζωής και είναι με διαφορά το πιο σεξουαλικά ενεργό και παραγωγικό αρσενικό στη Γη. Ο Ντιέγκο, μια χελώνα «μηχανή του σεξ», είναι ένας ζωντανός...
Επιστήμονες έβαλαν 3D γυαλιά σε σουπιά και της έδειξαν βίντεο –...
Οι σουπιές έχουν τη δυνατότητα να παρακολουθούν 3D ταινίες και να αντιδρούν σε αυτές σαν βλέπουν κάτι αληθινό στον ωκεανό.
Και όταν πρόκειται για την...
Ανακαλύφθηκε μυστηριώδες τεράστιο κύμα από «εκκολαπτήρια» άστρων
Aμερικανοί και άλλοι αστρονόμοι ανακάλυψαν μια άγνωστη έως τώρα τεράστια δομή στο γαλαξία μας, η οποία έχει μορφή κύματος και αποτελείται από πολλά διασυνδεμένα...
Eυρωπαϊκή Yπηρεσία Κοπέρνικος: Το 2019 ήταν η δεύτερη πιο ζεστή χρονιά...
Προβληματισμό προκαλούν τα στοιχεία της ευρωπαϊκής υπηρεσίας *Κοπέρνικος (Copernicus), η οποία περιγράφει «ανησυχητικές» ενδείξεις, καθώς το 2019 ήταν η δεύτερη πιο ζεστή χρονιά στον κόσμο, κλείνοντας μια δεκαετία...